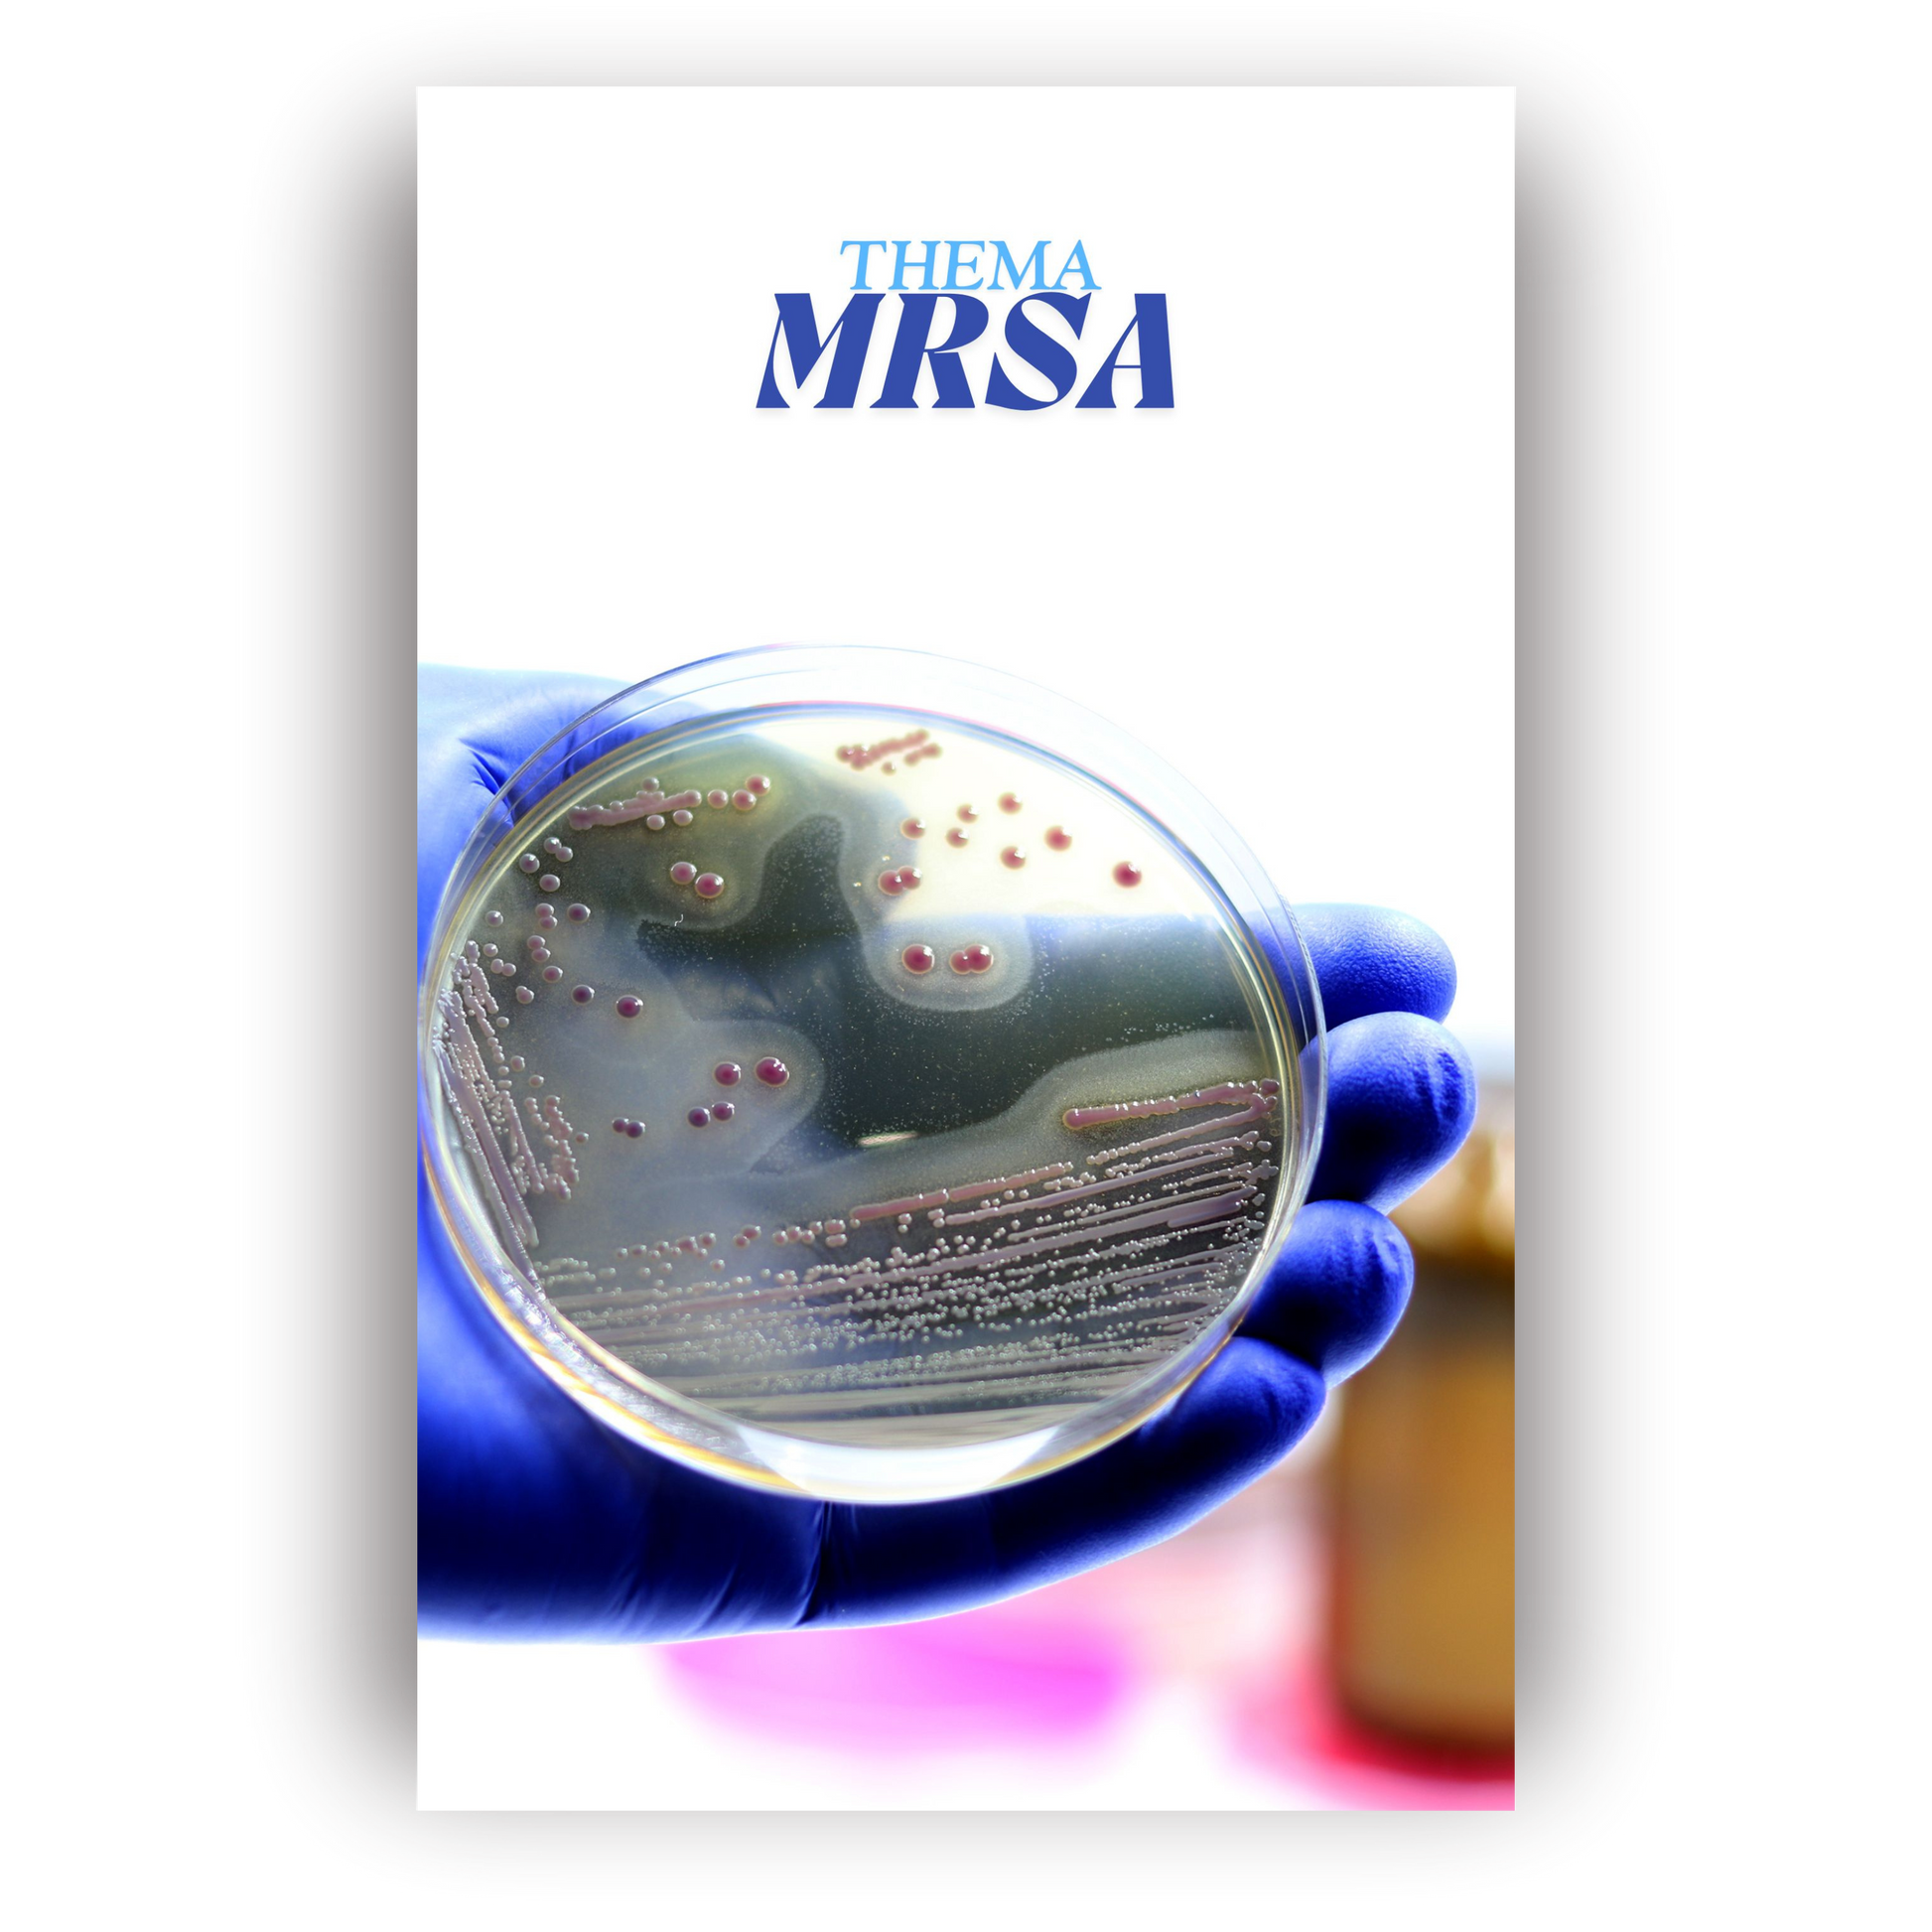

Ist das PDF eher für die Schule oder für die Praxis gedacht?
Beides! Das PDF wurde so gestaltet, dass du sowohl im Unterricht als auch auf Station etwas davon hast. Es vermittelt dir prüfungsrelevantes Wissen, gibt dir aber auch praxisnahe Tipps, Reflexionsfragen und Handlungshilfen – ideal für Lernphasen, Praxisanleiterstunden oder zur Nachbereitung nach dem Dienst.
Für welches Ausbildungsjahr ist das Buch geeignet?
Das Buch ist bewusst so aufgebaut, dass es dich durch alle Ausbildungsjahre begleitet. Die Inhalte sind leicht verständlich, aber inhaltlich vollwertig – egal ob du gerade erst anfängst oder kurz vor der Prüfung stehst. Viele nutzen es zum Einstieg, zum Wiederholen oder zum schnellen Nachschlagen vor Praxis- oder Theorieeinsätzen.
Wie unterscheidet sich dein Buch von normalen Lehrbüchern?
Dieses Buch wurde von jemandem geschrieben, der selbst jahrelang in der Pflege gearbeitet hat – mit Herz, Verstand und Humor. Es ist praxisnah, direkt, motivierend und ohne unnötigen Fachjargon. Du bekommst das Wesentliche auf den Punkt gebracht, viele Beispiele aus dem echten Pflegealltag und Lernhilfen, die wirklich funktionieren. Kein trockenes Schulbuch – sondern ein echtes Begleitbuch für deine Ausbildung.